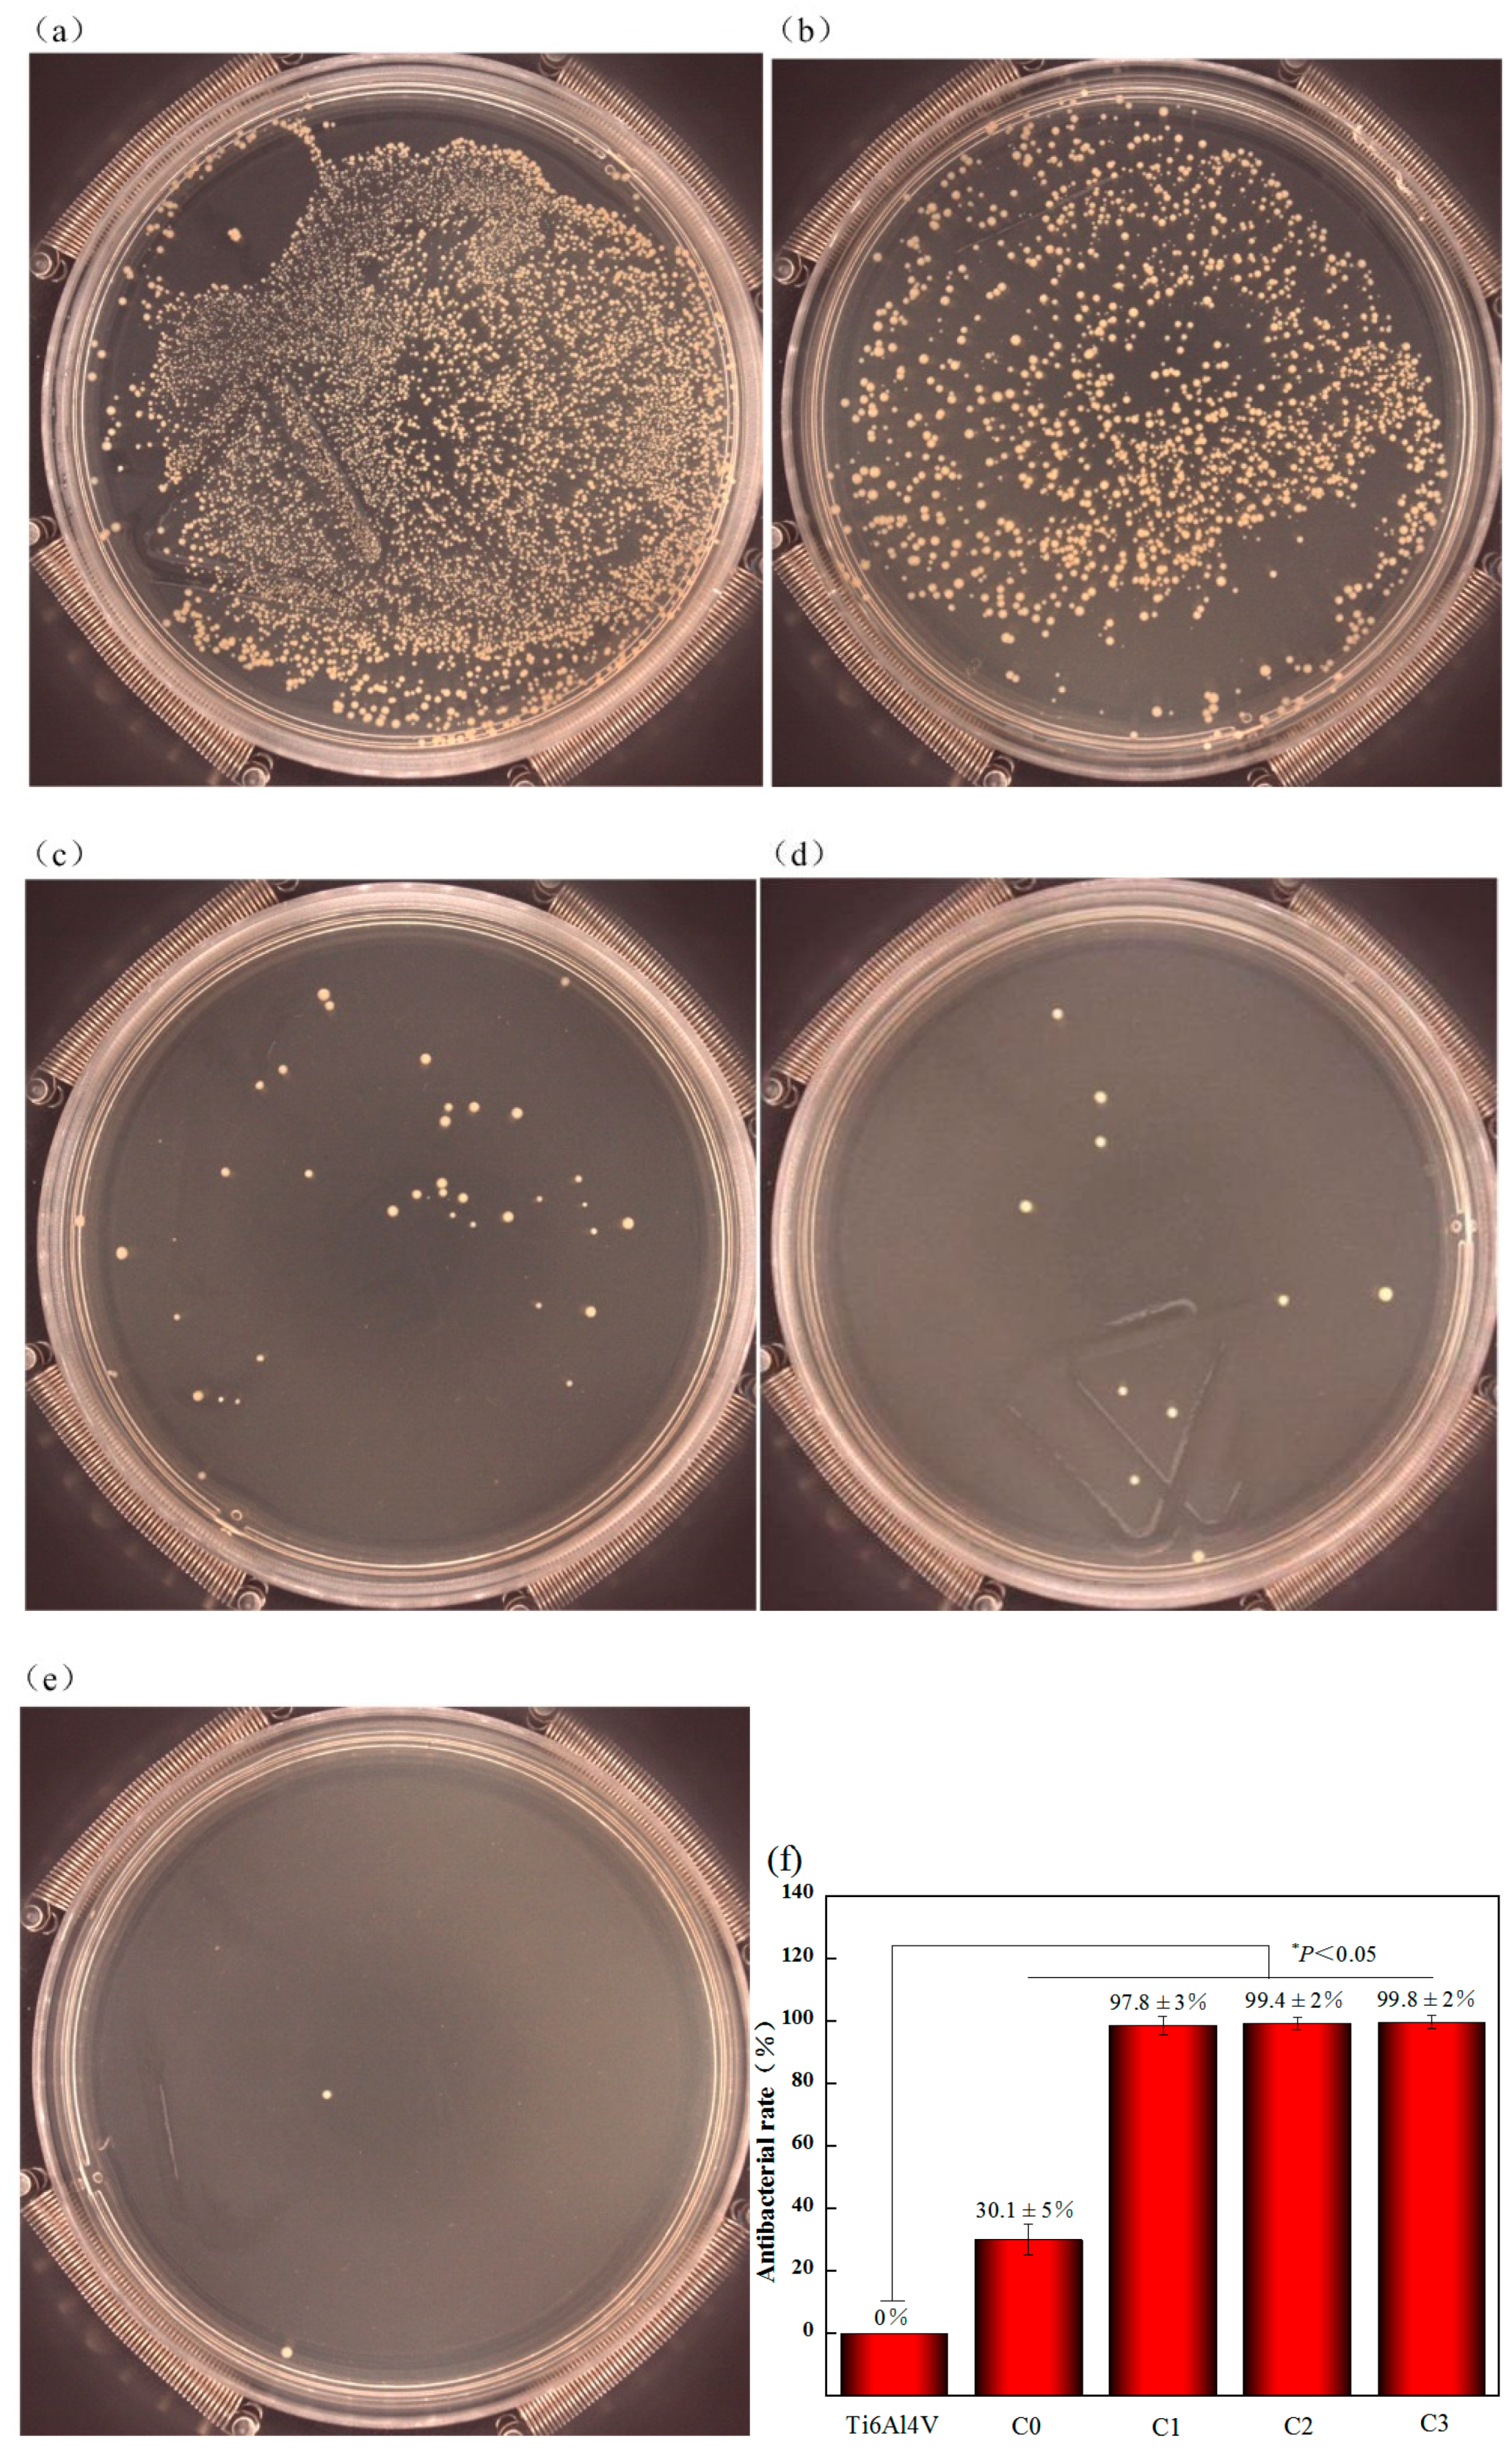
Biomolecules 10 00068 g011 Biomolecules 10 00068 g011

Microstructure, Wettability, Corrosion Resistance and Antibacterial Property of Cu-MTa2O5 Multilayer Composite Coatings with Different Cu Incorporation Contents
Abstract
1. Introduction
2. Materials and Methods
2.1. Coating Deposition
2.2. Coatings Characterization
2.3. Contact Angle Tests
2.4. Electrochemical Experiments
2.5. Antibacterial Test
3. Results and Discussion
3.1. Microstructure Characterization
3.2. Wettability
3.3. Anticorrosion Property
3.4. Antibacterial Properties
4. Conclusions
Author Contributions
Funding
Conflicts of Interest
References
- Badea, M.; Braic, M.; Kiss, A.; Moga, M.; Pozna, E.; Pana, I.; Vladescu, A. Influence of Ag content on the antibacterial properties of SiC doped hydroxyapatite coatings. Ceram. Int. 2016, 42, 1801–1811. [Google Scholar] [CrossRef]
- Duraipandy, N.; Syamala, K.M.; Rajendran, N. Antibacterial effects, biocompatibility and electrochemical behavior of zinc incorporated niobium oxide coating on 316L SS for biomedical applications. Appl. Surf. Sci. 2018, 427, 1166–1181. [Google Scholar]
- Zhang, X.; Wang, H.; Li, J.; He, X.; Hang, R.; Huang, X.; Tian, L.; Tang, B. Corrosion behavior of Zn-incorporated antibacterial TiO2 porous coating on titanium. Ceram. Int. 2016, 42, 17095–17100. [Google Scholar] [CrossRef]
- Xu, J.; Hu, W.; Xie, Z.H.; Munroe, P. Reactive-sputter-deposited β-Ta2O5 and TaON nanoceramic coatings on Ti–6Al–4V alloy against wear and corrosion damage. Surf. Coat. Technol. 2016, 296, 171–184. [Google Scholar] [CrossRef]
- Hu, X.; Neoh, K.G.; Zhang, J.; Kang, E.T. Bacterial and osteoblast behavior on titanium, cobalt-chromium alloy and stainless steel treated with alkali and heat: A comparative study for potential orthopedic applications. J. Colloid Interface Sci. 2014, 417, 410–419. [Google Scholar] [CrossRef]
- Raj, V.; Mumjitha, M.S. Fabrication of biopolymers reinforced TNT/HA coatings on Ti: Evaluation of its Corrosion resistance and Biocompatibility. Electrochim. Acta 2015, 153, 1–11. [Google Scholar] [CrossRef]
- Ding, Z.; He, Q.; Ding, Z.; Liao, C.; Chen, D.; Ou, L. Fabrication and Performance of ZnO Doped Tantalum Oxide Multilayer Composite Coatings on Ti6Al4V for Orthopedic Application. Nanomaterials 2019, 9, 685. [Google Scholar] [CrossRef]
- Varanasi, K.K.; Deng, T.; Smith, J.D.; Hsu, M.; Bhate, N. Frost formation and ice adhesion on superhydrophobic surfaces. Appl. Phys. Lett. 2010, 97, 234102. [Google Scholar] [CrossRef]
- Jiang, J.Y.; Xu, J.L.; Liu, Z.H.; Deng, L.; Sun, B.; Liu, S.D.; Wang, L.; Liu, H.Y. Preparation, corrosion resistance and hemocompatibility of the superhydrophobic TiO2 coatings on biomedical Ti-6Al-4V alloys. Appl. Surf. Sci. 2015, 347, 591–595. [Google Scholar] [CrossRef]
- Berni, M.; Lopomo, N.; Marchiori, G.; Gambardella, A.; Boi, M.; Bianchi, M.; Visani, A.; Pavan, P.; Russo, A.; Marcacci, M. Tribological characterization of zirconia coatings deposited on Ti6Al4V components for orthopedic applications. Mater. Sci. Eng. C 2016, 62, 643–655. [Google Scholar] [CrossRef]
- Khanna, R.; Kokubo, T.; Matsushita, T.; Takadama, H. Fabrication of dense α-alumina layer on Ti-6Al-4V alloy hybrid for bearing surfaces of artificial hip joint. Mater. Sci. Eng. C 2016, 69, 1229–1239. [Google Scholar] [CrossRef] [PubMed]
- Chellappa, M.; Vijayalakshmi, U. Electrophoretic deposition of silica and its composite coatings on Ti-6A1-4V, and its in vitro corrosion behaviour for biomedical applications. Mater. Sci. Eng. C 2017, 71, 879–890. [Google Scholar] [CrossRef] [PubMed]
- Kalisz, M.; Grobelny, M.; Mazur, M.; Wojcieszak, D.; Świniarski, M.; Zdrojek, M.; Domaradzki, J.; Kaczmarek, D. Mechanical and electrochemical properties of Nb2O5, Nb2O5: Cu and graphene layers deposited on titanium alloy (Ti6Al4V). Surf. Coat. Technol. 2015, 271, 92–99. [Google Scholar] [CrossRef]
- He, Q.; Liu, J.; Liang, J.; Liu, X.; Li, W.; Liu, Z.; Ding, Z.; Tuo, D. Towards Improvements for Penetrating the Blood-Brain Barrier-Recent Progress from a Material and Pharmaceutical Perspective. Cells 2018, 7, 24. [Google Scholar] [CrossRef]
- Hu, W.; Xu, J.; Lu, X.; Hu, D.; Tao, H.; Munroe, P.; Xie, Z.H. Corrosion and wear behaviours of a reactive-sputter-deposited Ta2O5 nanoceramic coating. Appl. Surf. Sci. 2016, 368, 177–190. [Google Scholar] [CrossRef]
- Alias, R.; Mahmoodian, R.; Rizwan, M.; Abd Shukor, M.H. Study the effect of thermal annealing on adhesion strength of Silver-Tantalum Oxide thin film deposited by reactive magnetron sputtering. J. Adhes. Sci. Technol. 2019, 33, 1626–1643. [Google Scholar] [CrossRef]
- Sarker, J.C.; Vasan, R.; Makableh, Y.F.; Lee, S.; Nusir, A.I.; Manasreh, M.O. Enhanced performance of surface modified InAs quantum dots solar cell by a sol–gel grown tantalum pentoxide antireflection coating. Sol. Energy Mater. Sol. Cells 2014, 127, 58–62. [Google Scholar] [CrossRef]
- Donkov, N.; Mateev, E.; Safonov, V.; Zykova, A.; Yakovin, S.; Kolesnikov, D.; Sudzhanskaya, I.; Goncharov, I.; Georgieva, V. Comparative analysis of electrophysical properties of ceramic tantalum pentoxide coatings, deposited by electron beam evaporation and magnetron sputtering methods. J. Phys. Conf. Ser. 2014, 558, 012036. [Google Scholar] [CrossRef]
- Shi, J.Z.; Chen, C.Z.; Yu, H.J.; Zhang, S.J. Application of magnetron sputtering for producing bioactive ceramic coatings on implant materials. Bull. Mater. Sci. 2008, 31, 877. [Google Scholar] [CrossRef]
- Tan, S.; Zhang, X.; Wu, X.; Fang, F.; Jiang, J. Comparison of chromium nitride coatings deposited by DC and RF magnetron sputtering. Thin Solid Films 2011, 519, 2116–2120. [Google Scholar] [CrossRef]
- Islam, M.; Inal, O.T. Synthesis and characterization of Al2O3 and SiO2 films with fluoropolymer content using rf-plasma magnetron sputtering technique. J. Vac. Sci. Technol. A Vac. Surf. Films 2008, 26, 198–204. [Google Scholar] [CrossRef]
- He, H.-B.; Li, H.-Y.; Xu, Z.-Z.; Kim, D.; Lyu, S.-K. Effect of MoS2-based composite coatings on tribological behavior and efficiency of gear. Int. J. Precis. Eng. Manuf. 2010, 11, 937–943. [Google Scholar] [CrossRef]
- Ellmer, K. Magnetron sputtering of transparent conductive zinc oxide: Relation between the sputtering parameters and the electronic properties. J. Phys. D Appl. Phys. 2000, 33, R17. [Google Scholar] [CrossRef]
- Meidanchi, A.; Jafari, A. Synthesis and characterization of high purity Ta2O5 nanoparticles by laser ablation and its antibacterial properties. Opt. Laser Technol. 2019, 111, 89–94. [Google Scholar] [CrossRef]
- Zhang, E.; Li, F.; Wang, H.; Liu, J.; Wang, C.; Li, M.; Yang, K. A new antibacterial titanium-copper sintered alloy: Preparation and antibacterial property. Mater. Sci. Eng. C 2013, 33, 4280–4287. [Google Scholar] [CrossRef] [PubMed]
- Ghosh, R.; Swart, O.; Westgate, S.; Miller, B.L.; Yates, M.Z. Antibacterial Copper-Hydroxyapatite Composite Coatings via Electrochemical Synthesis. Langmuir 2019, 35, 5957–5966. [Google Scholar] [CrossRef]
- Jaiswal, S.; McHale, P.; Duffy, B. Preparation and rapid analysis of antibacterial silver, copper and zinc doped sol-gel surfaces. Colloids Surf. B Biointerfaces 2012, 94, 170–176. [Google Scholar] [CrossRef]
- Vincent, M.; Duval, R.E.; Hartemann, P.; Engels-Deutsch, M. Contact killing and antimicrobial properties of copper. J. Appl. Microbiol. 2018, 124, 1032–1046. [Google Scholar] [CrossRef]
- Zhang, X.; Li, J.; Wang, X.; Wang, Y.; Hang, R.; Huang, X.; Tang, B.; Chu, P.K. Effects of copper nanoparticles in porous TiO2 coatings on bacterial resistance and cytocompatibility of osteoblasts and endothelial cells. Mater. Sci. Eng. C. 2018, 82, 110–120. [Google Scholar] [CrossRef]
- Ewald, A.; Kappel, C.; Vorndran, E.; Moseke, C.; Gelinsky, M.; Gbureck, U. The effect of Cu (II)-loaded brushite scaffolds on growth and activity of osteoblastic cells. J. Biomed. Mater. Res. Part A 2012, 100, 2392–2400. [Google Scholar] [CrossRef]
- Xiao, J.; Zhu, Y.; Huddleston, S.; Li, P.; Xiao, B.; Farha, O.K.; Ameer, G.A. Copper Metal-Organic Framework Nanoparticles Stabilized with Folic Acid Improve Wound Healing in Diabetes. ACS Nano 2018, 12, 1023–1032. [Google Scholar] [CrossRef] [PubMed]
- Tao, B.; Lin, C.; Deng, Y.; Yuan, Z.; Shen, X.; Chen, M.; He, Y.; Peng, Z.; Hu, Y.; Cai, K. Copper-nanoparticle-embedded hydrogel for killing bacteria and promoting wound healing with photothermal therapy. J. Mater. Chem. B 2019, 7, 2534–2548. [Google Scholar] [CrossRef]
- He, X.; Zhang, G.; Wang, X.; Hang, R.; Huang, X.; Qin, L.; Tang, B.; Zhang, X. Biocompatibility, corrosion resistance and antibacterial activity of TiO2/CuO coating on titanium. Ceram. Int. 2017, 43, 16185–16195. [Google Scholar] [CrossRef]
- Rosenbaum, J.; Versace, D.L.; Abbad-Andallousi, S.; Pires, R.; Azevedo, C.; Cénédese, P.; Dubot, P. Antibacterial properties of nanostructured Cu-TiO2 surfaces for dental implants. Biomater. Sci. 2017, 5, 455–462. [Google Scholar] [CrossRef] [PubMed]
- Huang, H.; Chang, Y.; Weng, J.; Chen, Y.; Lai, C.; Shieh, T. Anti-bacterial performance of Zirconia coatings on Titanium implants. Thin Solid Films 2013, 528, 151–156. [Google Scholar] [CrossRef]
- He, Q.; Liu, J.; Liu, X.; Li, G.; Chen, D.; Deng, P.; Liang, J. A promising sensing platform toward dopamine using MnO2 nanowires/electro-reduced graphene oxide composites. Electrochim. Acta 2019, 296, 683–692. [Google Scholar] [CrossRef]
- He, Q.; Tian, Y.; Wu, Y.; Liu, J.; Li, G.; Deng, P.; Chen, D. Facile and Ultrasensitive Determination of 4-Nitrophenol Based on Acetylene Black Paste and Graphene Hybrid Electrode. Nanomaterials 2019, 9, 429. [Google Scholar] [CrossRef]
- Au, A.; Ha, J.; Hernandez, M.; Polotsky, A.; Hungerford, D.S.; Frondoza, C.G. Nickel and vanadium metal ions induce apoptosis of T-lymphocyte Jurkat cells. J. Biomed. Mater. Res. Part A 2006, 79, 512–521. [Google Scholar] [CrossRef]
- Cao, H.; Liu, X.; Meng, F.; Chu, P.K. Biological actions of silver nanoparticles embedded in titanium controlled by micro-galvanic effects. Biomaterials 2011, 32, 693–705. [Google Scholar] [CrossRef]
- Costerton, J.W.; Stewart, P.S.; Greenberg, E.P. Bacterial biofilms: A common cause of persistent infections. Science 1999, 284, 1318–1322. [Google Scholar] [CrossRef]
- Ding, Z.; Wang, Y.; Zhou, Q.; Ding, Z.; Wu, Y.; Zhu, Y.; Shi, W.; He, Q. The Preparation and Properties of Multilayer Cu-MTa2O5 Composite Coatings on Ti6Al4V for Biomedical Applications. Nanomaterials 2019, 9, 1498. [Google Scholar] [CrossRef] [PubMed]
- Michael, T.; Urquhart, A.J.; Mischa, Z.; Davies, M.C.; Alexander, M.R. Picoliter water contact angle measurement on polymers. Langmuir 2007, 23, 6875. [Google Scholar]
- Kokubo, T.; Takadama, H. How useful is SBF in predicting in vivo bone bioactivity? Biomaterials 2006, 27, 2907–2915. [Google Scholar] [CrossRef] [PubMed]
- He, Q.; Liu, J.; Liu, X.; Li, G.; Chen, D.; Deng, P.; Liang, J. Fabrication of Amine-Modified Magnetite-Electrochemically Reduced Graphene Oxide Nanocomposite Modified Glassy Carbon Electrode for Sensitive Dopamine Determination. Nanomaterials 2018, 8, 194. [Google Scholar] [CrossRef]
- He, Q.; Wu, Y.; Tian, Y.; Li, G.; Liu, J.; Deng, P.; Chen, D. Facile electrochemical sensor for nanomolar rutin detection based on magnetite nanoparticles and reduced graphene oxide decorated electrode. Nanomaterials 2019, 9, 115. [Google Scholar] [CrossRef]
- Balashabadi, P.; Larijani, M.M.; Jafari-Khamse, E.; Seyedi, H. The role of Cu content on the structural properties and hardness of TiN–Cu nanocomposite film. J. Alloys Compd. 2017, 728, 863–871. [Google Scholar] [CrossRef]
- Cheng, Y.; Cao, L.; He, G.; Yao, G.; Song, X.; Sun, Z. Preparation, microstructure and photoelectrical properties of Tantalum-doped zinc oxide transparent conducting films. J. Alloys Compd. 2014, 608, 85–89. [Google Scholar] [CrossRef]
- Chan, K.Y.; Teo, B.S. Sputtering power and deposition pressure effects on the electrical and structural properties of copper thin films. J. Mater. Sci. 2005, 40, 5971–5981. [Google Scholar] [CrossRef]
- Wu, S.J.J.; Houng, B.; Huang, B.S. Effect of growth and annealing temperatures on crystallization of tantalum pentoxide thin film prepared by RF magnetron sputtering method. J. Alloys Compd. 2009, 475, 488–493. [Google Scholar] [CrossRef]
- Haque, S.M.; Sagdeo, P.R.; Shinde, D.D.; Misal, J.S.; Jha, S.N.; Bhattacharyya, D.; Sahoo, N.K. Extended X-ray absorption fine structure measurements on asymmetric bipolar pulse direct current magnetron sputtered Ta2O5 thin films. Appl. Opt. 2015, 54, 6744–6751. [Google Scholar] [CrossRef]
- Chen, H.; Ding, J.; Shi, F.; Li, Y.; Guo, W. Optical properties of Ti-doped ZnO films synthesized via magnetron sputtering. J. Alloys Compd. 2012, 534, 59–63. [Google Scholar] [CrossRef]
- Bright, T.J.; Watjen, J.I.; Zhang, Z.M.; Muratore, C.; Voevodin, A.A.; Koukis, D.I.; Tanner, D.B.; Arenas, D.J. Infrared optical properties of amorphous and nanocrystalline Ta2O5 thin films. J. Appl. Phys. 2013, 114, 083515. [Google Scholar] [CrossRef]
- Hsieh, J.H.; Yeh, T.H.; Li, C.; Chiu, C.H.; Huang, C.T. Antibacterial properties of TaN–(Ag, Cu) nanocomposite thin films. Vacuum 2013, 87, 160–163. [Google Scholar] [CrossRef]
- Huang, H.L.; Chang, Y.Y.; Chen, H.J.; Chou, Y.K.; Lai, C.H.; Chen, M.Y. Antibacterial properties and cytocompatibility of tantalum oxide coatings with different silver content. J. Vac. Sci. Technol. A Vac. Surf. Films 2014, 32, 02B117. [Google Scholar] [CrossRef]
- Kumar, A.M.; Khan, A.; Suleiman, R.; Qamar, M.; Saravanan, S.; Dafalla, H. Bifunctional CuO/TiO2 nanocomposite as nanofiller for improved corrosion resistance and antibacterial protection. Prog. Org. Coat. 2018, 114, 9–18. [Google Scholar] [CrossRef]
- Hong, R.; Wang, J.; Tao, C.; Zhang, D. Fabrication of single phase transparent conductive cuprous oxide thin films by direct current reactive magnetron sputtering. In Proceedings of the 2017 China Semiconductor Technology International Conference, Shanghai, China, 12–13 March 2017; IEEE: Piscataway, NJ, USA, 2017; pp. 1–6. [Google Scholar]
- Dave, P.Y.; Patel, K.H.; Chauhan, K.V.; Chawla, A.K.; Rawal, S.K. Examination of Zinc Oxide Films Prepared by Magnetron Sputtering. Procedia Technol. 2016, 23, 328–335. [Google Scholar] [CrossRef]
- Black, J. Biological performance of tantalum. Clin. Mater. 1994, 16, 167–173. [Google Scholar] [CrossRef]
- Raghupathy, Y.; Kamboj, A.; Rekha, M.Y.; Narasimha Rao, N.P.; Srivastava, C. Copper-graphene oxide composite coatings for corrosion protection of mild steel in 3.5% NaCl. Thin Solid Films 2017, 636, 107–115. [Google Scholar] [CrossRef]
- Patel, M.N.; Dosi, P.A.; Bhatt, B.S. Antibacterial, DNA interaction and superoxide dismutase activity of drug based copper (II) coordination compounds. Polyhedron 2010, 29, 3238–3245. [Google Scholar] [CrossRef]
- Cai, X.; Zhang, B.; Liang, Y.; Zhang, J.; Yan, Y.; Chen, X.; Wu, Z.; Liu, H.; Wen, S.; Tan, S.; et al. Study on the antibacterial mechanism of copper ion- and neodymium ion-modified alpha-zirconium phosphate with better antibacterial activity and lower cytotoxicity. Colloids Surf. B Biointerfaces 2015, 132, 281–289. [Google Scholar] [CrossRef]
- Chang, Y.; Huang, H.; Chen, H.; Lai, C.; Wen, C. Antibacterial properties and cytocompatibility of tantalum oxide coatings. Surf. Coat. Technol. 2014, 259, 193–198. [Google Scholar] [CrossRef]

| Layer Number | Coating Materials | Sputtering Power (W) | Deposition Time (min) | Gas Flow (sccm) | ||
|---|---|---|---|---|---|---|
| Ar | O2 | |||||
| 1st layer | Ti | 200 | 8 | 20 | ||
| 2nd layer | TiO2 | 200 | 8 | 16 | 4 | |
| 3rd layer | TiO2-Ta2O5 | TiO2 | 200 | 8 | 20 | 5 |
| Ta2O5 | 200 | |||||
| 4th layer | Ta2O5 | 200 | 105 | 20 | ||
| 5th layer | Cu-Ta2O5 | Cu | 0, 40, 60, 80 | 15 | 20 | |
| Ta2O5 | 200 | |||||
© 2019 by the authors. Licensee MDPI, Basel, Switzerland. This article is an open access article distributed under the terms and conditions of the Creative Commons Attribution (CC BY) license (http://creativecommons.org/licenses/by/4.0/).
Share and Cite
Ding, Z.; Wang, Y.; Zhou, Q.; Ding, Z.; Liu, J.; He, Q.; Zhang, H. Microstructure, Wettability, Corrosion Resistance and Antibacterial Property of Cu-MTa2O5 Multilayer Composite Coatings with Different Cu Incorporation Contents. Biomolecules 2020, 10, 68. https://doi.org/10.3390/biom10010068
Ding Z, Wang Y, Zhou Q, Ding Z, Liu J, He Q, Zhang H. Microstructure, Wettability, Corrosion Resistance and Antibacterial Property of Cu-MTa2O5 Multilayer Composite Coatings with Different Cu Incorporation Contents. Biomolecules. 2020; 10(1):68. https://doi.org/10.3390/biom10010068
Chicago/Turabian StyleDing, Zeliang, Yi Wang, Quan Zhou, Ziyu Ding, Jun Liu, Quanguo He, and Haibo Zhang. 2020. "Microstructure, Wettability, Corrosion Resistance and Antibacterial Property of Cu-MTa2O5 Multilayer Composite Coatings with Different Cu Incorporation Contents" Biomolecules 10, no. 1: 68. https://doi.org/10.3390/biom10010068
APA StyleDing, Z., Wang, Y., Zhou, Q., Ding, Z., Liu, J., He, Q., & Zhang, H. (2020). Microstructure, Wettability, Corrosion Resistance and Antibacterial Property of Cu-MTa2O5 Multilayer Composite Coatings with Different Cu Incorporation Contents. Biomolecules, 10(1), 68. https://doi.org/10.3390/biom10010068

